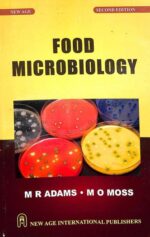

Food Microbiology
| Author | , |
|---|---|
| Publisher | |
| Language | |
| Edition |
2022 |
| ISBN |
9788122479263 |
| Cover |
Paperback |
| Size |
16*4*24(L*B*H) |
| Weight |
690gm |
| Item Code |
9788122479263 |
Original price was: ₹480.00.₹385.00Current price is: ₹385.00.
![]() Available
Available
6 in stock
This widely acclaimed text covers the whole field of modern food microbiology. Now in its second edition, it has been revised and updated throughout and includes new sections on stress response, Mycobacterium spp., risk analysis and new foodborne health problems such as BSE. Food Microbiology covers the three main aspects of interaction between micro-organisms and food – spoilage, foodborne illness and fermentation – and the positive and negative features that result. It discusses the factors affecting the presence of micro-organisms in food and their capacity to survive and grow. Also included are recent developments in procedures used to assay and control the microbiological quality of food. Food Microbiology presents a thorough and accessible account of this increasingly topical subject, and is an ideal text for undergraduate courses in the biological sciences, biotechnology and food science. It will also be valuable as a reference for lecturers and researchers in these areas.
| Weight | 0.78 kg |
|---|---|
| Dimensions | 24 × 16 × 4 cm |
| Author | , |
| Publisher | |
| Language | |
| Edition |
2022 |
| ISBN |
9788122479263 |
| Cover |
Paperback |
| Size |
16*4*24(L*B*H) |
| Weight |
690gm |
| Item Code |
9788122479263 |

Laghu Siddhant Kaumudi लघुसिद्धान्तकौमुदि
₹545.00Original price was: ₹545.00.₹449.00Current price is: ₹449.00.